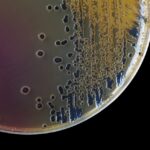

2023
 Is IgA deficiency a feature of canine atopic dermatitis in small and medium sized dogs?
Is IgA deficiency a feature of canine atopic dermatitis in small and medium sized dogs?
MDR Grant: £39,365
Institution: Scottish Rural College/University of Edinburgh
2022
 Assessing the effect of D-mannose on clinical outcome and microbiota composition in canine chronic inflammatory enteropathy
Assessing the effect of D-mannose on clinical outcome and microbiota composition in canine chronic inflammatory enteropathy
CRP Grant: £9,409.36
Institution: University of Edinburgh
 Evaluation of synovial cytokine concentrations in dogs with degenerative joint disease, immune mediated polyarthritis and septic arthritis
Evaluation of synovial cytokine concentrations in dogs with degenerative joint disease, immune mediated polyarthritis and septic arthritis
CRP Grant: £2,000
Institution: Vet4Life, Teddington
 Reusable vs disposable drapes: does their use affect post-operative wound complication rates in routine surgeries?
Reusable vs disposable drapes: does their use affect post-operative wound complication rates in routine surgeries?
CRP Grant: £9,053
Institution: Vet Partners, York
 Assessment of hypercoagulability in dogs with ischaemic cerebrovascular infarcts
Assessment of hypercoagulability in dogs with ischaemic cerebrovascular infarcts
CRP Grant: £7,566
Institution: RVC
 Effectiveness of low-level laser therapy for the treatment of osteoarthritis-associated pain in client-owned dogs
Effectiveness of low-level laser therapy for the treatment of osteoarthritis-associated pain in client-owned dogs
CRP Grant: £10,000 (including £5,000 from The Debs Foundation)
Institution: Cambridge University
 Investigating the potential of phage therapy to tackle Pseudomonas aeruginosa infections in dogs
Investigating the potential of phage therapy to tackle Pseudomonas aeruginosa infections in dogs
MDR Grant: £35,560
Institution: Edinburgh University
 Acute phase protein and micro RNA signatures for the diagnosis and prognosis of feline infectious peritonitis
Acute phase protein and micro RNA signatures for the diagnosis and prognosis of feline infectious peritonitis
MDR Grant: £39,865
Institution: Edinburgh University
Find out more and help with case recruitment
 Autoimmune encephalitis in cats: beyond the tip of the iceberg
Autoimmune encephalitis in cats: beyond the tip of the iceberg
MDR Grant: £39,961.60
Institution: Oxford University
 Exploring the dog microbiome for therapeutic potential of skin disease
Exploring the dog microbiome for therapeutic potential of skin disease
SRP Grant: £3000
Institution: Liverpool University
 Investigating the potential therapeutic effects of senolytic drugs in canine myxomatous mitral valve disease (MMVD)
Investigating the potential therapeutic effects of senolytic drugs in canine myxomatous mitral valve disease (MMVD)
SRP Grant: £1857
Institution: Edinburgh University
 Feasibility of using a point-of-care analyser for faecal calprotectin to differentiate different intestinal disease in cats
Feasibility of using a point-of-care analyser for faecal calprotectin to differentiate different intestinal disease in cats
SRP Grant: £2890
Institution: Edinburgh University
 Characterising the virus neutralising antibody response to SARS-CoV-2 in the UK feline population and examining changes in seroprevalence during the different phases of the pandemic
Characterising the virus neutralising antibody response to SARS-CoV-2 in the UK feline population and examining changes in seroprevalence during the different phases of the pandemic
SRP Grant: £2771
Institution: Glasgow University
2021
 Do measurements of circulating fibrosis markers change with disease progression in canine myxomatous mitral valve disease?
Do measurements of circulating fibrosis markers change with disease progression in canine myxomatous mitral valve disease?
CRP Grant (joint-funded by the Veterinary Cardiovascular Society): £9953
Institution: Bristol University
 Cotton wool versus non-woven gauze swabs: comparatively which is more efficacious for minimising the preoperative microbial load on the ovariohysterectomy surgical site in bitches?
Cotton wool versus non-woven gauze swabs: comparatively which is more efficacious for minimising the preoperative microbial load on the ovariohysterectomy surgical site in bitches?
SRP Grant: £2050
Institution: Harper Adams University
 Effect of deformed skull base morphology on nasopharyngeal narrowing and BOAS severity in pugs, French bulldogs, and bulldogs
Effect of deformed skull base morphology on nasopharyngeal narrowing and BOAS severity in pugs, French bulldogs, and bulldogs
SRP Grant: £2300
Institution: University of Cambridge
 Exploring recording of adverse drug reaction reporting in veterinary free-text clinical narratives
Exploring recording of adverse drug reaction reporting in veterinary free-text clinical narratives
SRP Grant: £2300
Institution: University of Liverpool
 What is the role of urinary extracellular vesicles in the pathogenesis of canine urinary tract infection and asymptomatic bacteriuria?
What is the role of urinary extracellular vesicles in the pathogenesis of canine urinary tract infection and asymptomatic bacteriuria?
SRP Grant: £2500
Institution: University of Cambridge
 The characterisation and clinical significance of intestinal fibrosis in cats with chronic inflammatory enteropathy
The characterisation and clinical significance of intestinal fibrosis in cats with chronic inflammatory enteropathy
MDR Grant: £40,000
Institution: RVC
 The roles of ageing and myxomatous mitral valve disease in vascular dysfunction in dogs
The roles of ageing and myxomatous mitral valve disease in vascular dysfunction in dogs
MDR Grant: £38,715
Institution: University of Edinburgh
 Fungal dysbiosis following antibacterial monotherapy in canine otitis externa
Fungal dysbiosis following antibacterial monotherapy in canine otitis externa
CRP Grant: £6650
Institution: RVC
 Comparison of the performance of a smartphone facilitated manually adjusted target controlled infusion of propofol in comparison with a conventional variable rate infusion in dogs undergoing elective surgical procedures
Comparison of the performance of a smartphone facilitated manually adjusted target controlled infusion of propofol in comparison with a conventional variable rate infusion in dogs undergoing elective surgical procedures
CRP Grant: £9750
Institution: University of Surrey
 Embryonic stem cell markers to identify mast cell tumour nodal metastases in dogs: a pilot study
Embryonic stem cell markers to identify mast cell tumour nodal metastases in dogs: a pilot study
CRP Grant: £9961.50
Institution: University of Edinburgh
 Ex vivo assessments of cell salvage and swab washing devices
Ex vivo assessments of cell salvage and swab washing devices
CRP Grant: £9944.14
Institution: University of Surrey / Fitzpatrick Referrals
 Pathways to waterways for imidacloprid in Seresto collars
Pathways to waterways for imidacloprid in Seresto collars
CRP Grant: £5154
Institution: University of Sussex
The susceptibility of Staphylococcus pseudintermedius to fluoroquinolones and their suitability for treating infections with methicillin resistant Staphylococcus pseudintermedius (MRSP): a pilot study
The susceptibility of Staphylococcus pseudintermedius to fluoroquinolones and their suitability for treating infections with methicillin resistant Staphylococcus pseudintermedius (MRSP): a pilot study
CRP Grant: £5818.71
Institution: University of Liverpool
2020
 Determining predictive metabolomic biomarkers for meniscal injuries in dogs with cranial cruciate ligament rupture using stifle joint synovial fluid
Determining predictive metabolomic biomarkers for meniscal injuries in dogs with cranial cruciate ligament rupture using stifle joint synovial fluid
MDR Grant: £32,927
Institution: Liverpool University
 A mixed methods approach to quantifying and characterising vaccine uptake and vaccine hesitancy in UK companion animals
A mixed methods approach to quantifying and characterising vaccine uptake and vaccine hesitancy in UK companion animals
Part-funded PhD: £50,000
Institution: Liverpool University
 Can we use bacterial outer membrane vesicles as a novel anti-bacterial therapy?
Can we use bacterial outer membrane vesicles as a novel anti-bacterial therapy?
SRP Grant: £2500
Institution: Cambridge University
 Feline lymphoma of the nervous system: a retrospective study (2003-2018)
Feline lymphoma of the nervous system: a retrospective study (2003-2018)
SRP Grant: £1600
Institution: RVC
 Pathogens and antimicrobial resistance in raw meat diets for dogs
Pathogens and antimicrobial resistance in raw meat diets for dogs
SRP Grant: £2500
Institution: Liverpool University
 Characterising implant-associated infection and aseptic loosening of total hip replacements in a large cohort of dogs from the BVOA-UoL canine hip registry
Characterising implant-associated infection and aseptic loosening of total hip replacements in a large cohort of dogs from the BVOA-UoL canine hip registry
SRP Grant: £2500
Institution: Bristol University
 Improving recognition, diagnosis and treatment of cats with seizures due to autoantibodies of the central nervous system, a treatable cause of feline seizures and status epilepticus
Improving recognition, diagnosis and treatment of cats with seizures due to autoantibodies of the central nervous system, a treatable cause of feline seizures and status epilepticus
CRP Grant: £8000
Institution: Oxford University
 Beta-adrenergic receptor expression in canine haemangiosarcomas – search for a new potential therapeutic intervention
Beta-adrenergic receptor expression in canine haemangiosarcomas – search for a new potential therapeutic intervention
CRP Grant: £7830
Institution: Nottingham University
 An investigation of novel immunohistochemical markers and serum auto-antibodies in cats with chronic biliary tract disease
An investigation of novel immunohistochemical markers and serum auto-antibodies in cats with chronic biliary tract disease
MDR Grant: £34,844
Institution: Cambridge University
